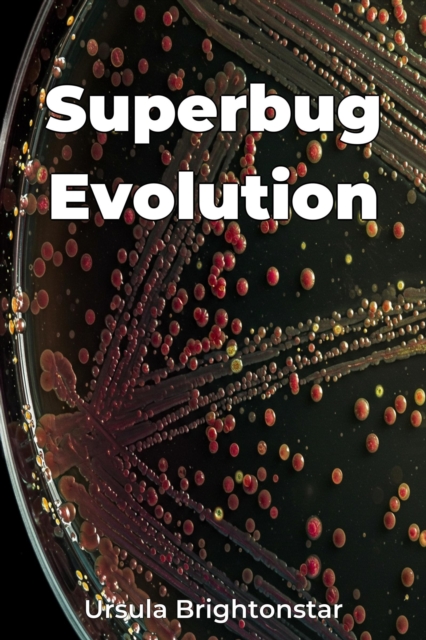
Superbug Evolution

Superbug Evolution
Superbug Evolution explores the escalating crisis of antimicrobial resistance, focusing on multidrug-resistant organisms and their impact on global healthcare. It examines the evolutionary mechanisms driving antibiotic resistance, revealing how widespread antibiotic use in medicine and agriculture inadvertently fosters the development of superbugs. The book highlights that superbug emergence is no...
Superbug Evolution explores the escalating crisis of antimicrobial resistance, focusing on multidrug-resistant organisms and their impact on global healthcare. It examines the evolutionary mechanisms driving antibiotic resistance, revealing how widespread antibiotic use in medicine and agriculture inadvertently fosters the development of superbugs. The book highlights that superbug emergence is no...
